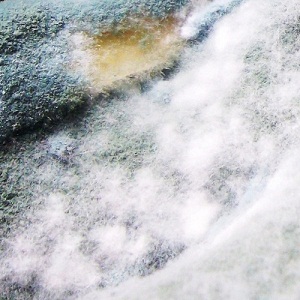

Микозы внутренних органов это заболевание, возбудителем которого являются грибки (плесневые грибки, аспергиллус, грибки семейства мукоровых, пенициллиум).
В основном эти грибки безопасны, а инфицирование наступает в организмах которые ослабленные другими болезнями или люди которые много работают в среде где повышена присутствие грибком.
Примером может служить работники в сфере выращивания грибов вёшенки, такие люди часто болеют пенициллиозом.
Что такое микозы внутренних органов их разновидности
Современные торговые, культурные и транспортные связи между государствами привели к проникновению в нашу страну ряда возбудителей микозов, с которыми мы прежде не встречались.
Специалисты за рубежом, особенно в тропической зоне, подвержены опасности заражения экзотическими для нас грибковыми заболеваниями.
Наряду с этим некоторые социально-экологические факторы последних десятилетий способствовали распространению среди людей неизвестных ранее форм грибковых заболеваний.
Отдельные представители грибковой флоры, прежде не игравших особой роли в патологии человека, ныне зарегистрированы как активные возбудители болезней.
Непатогенные в обычных условиях грибки при определенной ситуации (массивное инфицирование и т. п.) оказываются способными поражать не только кожные покровы людей, но и внутренние органы. Многие микозы возникают, как правило, на фоне хронических заболеваний, особенно у пожилых или ослабленных тяжелыми болезнями людей.
В прошлом из-за недостаточно налаженной диагностики микозы внутренних органов часть их проходила мимо внимания врачей и принималась за другие заболевания. Недаром среди микологов и врачей других специальностей бытует выражение: «В сомнительных случаях подозревай микозы!»
И такая настороженность нередко оказывается оправданной. Остановимся на некоторых грибковых заболеваниях, поражающих не только кожу, но и внутренние органы. Речь пойдет о плесневых микозах, имеющих относительно широкое распространение.
Почему появляются микозы внутренних органов
Каждый из нас наверняка встречал пушистый налет белого, зеленого или темного цвета на гниющих фруктах, овощах, других продуктах, находившихся в темном и влажном месте.
Нередко кожистая пленка плесени образуется на поверхности варенья, маринадов. Стоит дунуть на сухую плесень, как поднимается целое облако спор — потенциальных источников заражения.
Большинство плесеней безопасны для человека. Но отдельные виды могут, при определенных условиях вызывать поражения кожи, слизистых, ногтей и даже внутренних органов.
В последние годы участились поражения людей плесневыми грибками. Это во многом объясняется широким применением различных антибиотиков, кортикостероидов и других препаратов, вызывающих изменения нормальной микрофлоры организма ( дисбактериоз ) и создающих условия для размножения плесеней на поверхности тела и в тканях.
Плесневые поражения могут возникать эндогенно, когда сапрофитные грибки приобретают в силу различных обстоятельств (в том числе и тех, о которых только что говорилось) вирулентные свойства.
К плесневым микозам относятся аспергиллез, мукороз, пенициллез и некоторые другие грибковые заболевания.
Аспергиллез
В 1847 году знаменитый немецкий патолог Р. Вирхов обнаружил рост грибков — аспергиллов в тканях трупа женщины, погибшей с явлениями, сходными с туберкулезом лёгких.
В последующем было описано еще ряд таких случаев и сейчас стало очевидным, что прежние микологические находки были не случайны и врачи, видимо, имели дело с аспергиллезом.
Чем вызывается заболевание аспергиллез
Это заболевание вызывается грибками рода Аспергиллус — весьма многочисленными представителями грибков, которые встречаются повсеместно.
Известно, например, что в одном грамме почвы содержится до 100 тыс. зародышей грибков и значительную их часть составляют аспергиллы. Они легко попадают на растения, животных, различные предметы быта и продукты.
Эти грибки поражают растения, животных и людей на самых различных континентах. Как правило, заболевание не контагиозно, то есть не передается от человека к человеку.
Но это не снижает его значения. Эпидемиологи видят большую угрозу в связи со значительным распространением этого рода грибков и тяжелым течением вызываемой ими болезни.
Инфицирование происходит чаще всего с пылью респираторно, реже алиментарным путем (через рот), а также при повреждении кожи и слизистых.
Аспергиллез легких наблюдается как профессиональное заболевание при производстве органических кислот (где используются грибки Аспергиллус), ферментов, у рабочих пивоваренной, хлопчатобумажной промышленности, у персонала элеваторов, зернохранилищ.
Проблема аспергиллезов важна и в сельском хозяйстве. Нередко аспергиллезом болеют домашние животные и птицы, они же служат дополнительным источником распространения возбудителей.
Чем проявляется аспергиллез
Наиболее часто встречаются отомикозы — поражение кожи наружного слухового прохода. Проявляются они гиперемией и инфильтрацией кожи, иногда понижением слуха за счет образования корочек-чешуек и сужения слухового прохода.
Сильный зуд и повышенная чувствительность кожи в области ушной раковины, а иногда и раздражающий звон в ушах вызывают неприятные ощущения у больных аспергиллезом.
Отделяемое из ушей без запаха, цвет его зависит от вида грибка: черный при поражении А. нигер, желтый — при А. флавус, серый — при А. фумигатус.
Опасность заболевания
Опасность заболевания обусловливается переходом аспергиллеза наружного слухового прохода на барабанную перепонку с распространением на область среднего уха.
Характерными симптомами являются зуд, звон в ушах, иногда отмечаются колющие, жгучие боли, порою головные боли, повышение температуры.
Вначале стенки наружного слухового прохода воспалены, обильно покрыты слущенным эпителием серого цвета, переходящим и на барабанную перепонку.
Массы спор могут частично или полностью закрыть слуховой проход, вызывая тем самым ощущения звона и шума в ушах, ухудшение слуха.
Поражение костей аспергиллезом
Аспергиллез может поражать и костную систему. Чаще всего такое поражение наблюдается в области ребер и позвоночника (особенно его шейного и грудного отделов) и является результатом перехода процесса из легких на близлежащую костную ткань.
При таких поражениях у больных может развиться кифоз (искривление позвоночника).
Поражения кожи
Поражения кожи при аспергиллезе весьма разнообразны: от проявлений типа шелушения, опрелостей, паронихий (воспалений околоногтевого валика), экзематозных высыпаний до выраженных язвенных изменений ножи, подкожных абсцессов на лице, шее, конечностях, ягодицах.
Поражение стоп характеризуется плотными узлами на их тыле и подошве, которые затем размягчаются, изъязвляются и распадаются с образованием свищей, заполненных гнойным отделяемым со скоплениями разного цвета (в зависимости от пигмента аспергилла).
Нередко вследствие травмы ног (например, когда дети босиком бегают по лесу, лугу или попадают в болото) поражается и костная основа стопы. Встречаются и пораженные ногти (чаще всего наиболее травмируемых первых пальцев стоп).
Другие заболевания аспергиллеза
Кроме указанных форм аспергиллеза встречаются заболевания глаз, протекающие в виде блефарита, конъюнктивита, кератита.
Грибковые заболевания слизистых оболочек рта, носоглотки также не являются редкостью. Опасны аспергиллезные пневмонии и опухолеподобная форма локализованного аспергиллеза легких — аспергиллема.
Последние проявляются кровохарканьем, кашлем и другими симптомами поражения легких. Аллергический аспергиллез легких проявляется астматоидными приступами, вызванными сенсибилизацией организма к аллергенам грибков.
Профессор В. М. Лещенко показал развитие аутоинфекции (самозаражение) этим грибком и описал вспышки острых аспергиллезных интоксикаций, связанных с образованием грибками токсинов (например, в пищевых продуктах).
Профилактика заболевания
Профилактика аспергиллеза, как и большинства других плесневых микозов, сводится к предотвращению распыления спор грибков, пользованию спецодеждой и респираторами при работе, связанной с плесневым загрязнением, профилактике кожных травм и гигиене тела (мытье после загрязнения поверхности тела пылью и т. п.).
Учитывая, что аспергиллез часто возникает как осложнение при нерациональном лечении антибиотиками широкого спектра действия, разработаны полиантибиотики, содержащие в своем составе наряду, с основным антибиотиком противогрибковое средство — нистатин.
Инфицирование аспергиллезом
Известны аэрогенный, контактный, алиментарный пути заражения спорами грибка, а также аутоинфекция. Ученые говорят о профессиях, при которых чаще возникают заболевания аспергиллезом.
К ним относятся работающие на фабриках по обработке овощей, по производству лимонной кислоты, солода, пива, рабочие элеваторов, лаборанты и прочие работники, имеющие контакт с плесневыми грибками.
На производствах, связанных с применением культур аспергиллов (в качестве продуцентов различных полезных для промышленности и быта продуктов), как правило, предусмотрены необходимые элементы механизации, герметизации технологических процессов, исключающие непосредственный контакт человека со спорами плесневого грибка.
Это относится в известной степени к зернохранилищам, солодовням и другим объектам, где возможен близкий контакт человека с плесенями. Аналогичны меры профилактики и по отношению других плесневых микозов.
Мукороз
Это инфецирование различными видами грибков семейства мукоровых, которые весьма широко распространены в природе и встречаются в почве, навозе, органических остатках, прелом сене. Мукорозом болеют домашние животные и птицы. Он распространен и среди диких грызунов.
У людей мукороз встречается при выраженном снижении защитных сил организма на почве перенесенных тяжелых и хронических заболеваний или в силу других причин.
Клинические проявления аналогичны аспергиллезу и сводятся к признакам поражения кожи, подкожной клетчатки, висцеральных органов.
Возможно септическое течение болезни. Нередки поражения легких, слизистых носа, придаточных пазух (гайморит и др.). Встречаются также и поверхностные заболевания кожи, ногтей, наружного слухового прохода.
Дерматологами описаны профессиональные мукорозные поражения ногтей и околоногтевых валиков у сборщиков фруктов. Замечено преобладание таких поражений у больных диабетом, болезнями крови, в особенности после длительного лечения кортикостероидами и антибиотиками.
Пенициллиоз
При этом микозе наблюдаются поражения кожи, ногтей, наружных слуховых проходов, слизистых оболочек и некоторых внутренних органов, вызванные плесневыми грибками Пенициллиум.
Впервые пенициллиоз описан еще в прошлом веке (речь шла о поражении слухового прохода), а в начале века патогенные грибки Пенициллиум были обнаружены при циститах и бронхо-легочных заболеваниях. Пенициллиоз встречается во всем мире, но преобладает в тропических странах.
Грибки Пенициллиум широко применяются в пищевой и химической промышленности, например, при изготовлении сыров, органических кислот, ферментов, а также при производстве антибиотиков, и поэтому могут быть причиной профессиональной заболеваемости.
Заражение пенициллиозом происходит различными путями: в основном аэрогенно и при проникновении грибков через наружные покровы (при травмах кожи и т. п.), реже алиментарно — с пищей, например, с заплесневелыми сырами и другими продуктами, особенно овощами и фруктами.
Как избавиться от пенициллиоза
Клиника заболеваний сходна с проявлениями аспергиллеза. Для лечения пенициллиоза используют противогрибковые средства, в частности амфотерицин, амфоглюкамин, леворин, нистатин, а также йодистый калий.
Профилактике пенициллиоза, как и других плесневых микозов в быту, заключается в недопущении заплесневения домашней и особенно кухонной обстановки, предметов оборудования, пищи.
Одной из разновидностей поражения плесенью человека является мицетома стопы (мадурская стопа). Заболевание было описано в индийской провинции Мадура, но впоследствии оказалось, что этот синдром встречается практически повсеместно (чаще в тропиках), в том числе и в СНГ.
Заражение происходит при попадании грибков в рану. Начальные симптомы заболевания разнообразны, но позже процесс распространяется на мышцы, сухожилия, кости.
В результате хронического течения болезни возникает необходимость ампутации стопы. При ограниченных проявлениях заболевания эффективно иссечение первичных очагов.
Статья на тему Микозы внутренних органов

Добавить комментарий
Для отправки комментария вам необходимо авторизоваться.